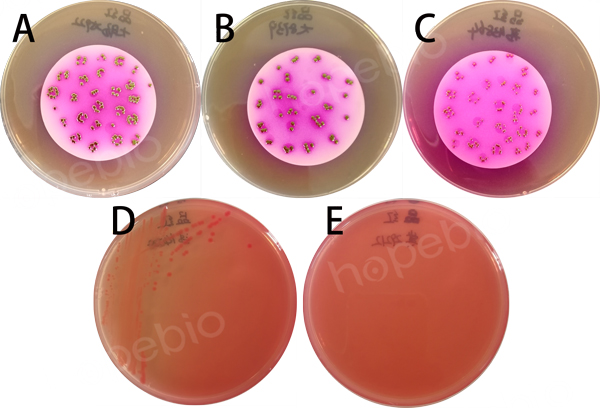
大肠埃希氏菌检验,水中大肠埃希菌的五种类型鉴别

一、大肠埃希氏菌情况简要介绍
大肠埃希氏菌(Escherichia coli,E. coli)为埃希氏菌属(Escherichia)代表菌。一般多不致病,广泛存在于人和温血动物的肠道中。
大肠埃希氏菌为革兰氏阴性短杆菌,大小0.5×1~3微米。周生鞭毛,能运动,无芽孢。能发酵多种糖类产酸、产气,是人和动物肠道中的正常栖居菌,婴儿出生后即随哺乳进入肠道,与人终身相伴,几乎占粪便干重的1/3。国家规定,每毫升饮用水中的菌落总数小于100,每100毫升水中不得检出总大肠菌群。
二、参考标准
《GBT5750.12-2006生活饮用水标准检验方法微生物指标:大肠埃希氏菌》 点击*载下**
三、检验方法以及结果分析
3.1大肠埃希氏菌多管发酵法
大肠埃希氏菌多管发酵法是指多管发酵法总大肠菌群阳性,在含有荧光底物的培养基上44.5℃培养24 h产生葡萄糖醛酸酶(β-glucuronidase),分解荧光底物释放出荧光产物,使培养基在紫外光下产生特征性荧光的细菌,以此来检测水中大肠埃希氏菌的方法。
3.1.1 检验步骤
3.1.1.1 乳糖发酵试验
(1)取10mL水样接种到10mL双料乳糖蛋白胨培养液中,取1mL水样接种到10mL单料乳糖蛋白胨培养液中,另取1mL水样注入到9mL灭菌生理盐水中,混匀后吸取1mL(即0.1mL水样)注入到10mL单料乳糖蛋白胨培养液中,每一稀释度接种5管。
对已处理过的出厂自来水,需经常检验或每天检验一次的,可直接种5份10mL水样双料培养基,每份接种10mL水样。
检验水源水时,如污染较严重,应加大稀释度,可接种1、0.1、0.01mL甚至0.1、0.01、0.001mL,每个稀释度接种5管,每个水样共接种15管。接种1mL以下水样时,必须作10倍递增稀释后,取1mL接种,每递增稀释一次,换用1支1mL灭菌刻度吸管。
(2)将接种管置36℃±1℃培养箱内,培养24h±2h。如有产酸产气者,则按下列步骤进行。

图1 乳糖蛋白胨培养基微生物质控结果
3.1.1.2 EC-MUG培养基试验
用烧灼灭菌的金属接种环或无菌棉签将上述试管中液体接种到EC-MUG管中。将已接种的EC-MUG管在培养箱或恒温水浴中44.5℃±0.5℃培养24h±2h。如使用恒温水浴,在接种后30min内进行培养,使水浴的液面超过EC-MUG管的液面。
3.1.2 结果观察与报告
将培养后的EC-MUG管在暗处用波长为366nm功率为6W的紫外光灯照射,如果有蓝色荧光产生则表示水样中含有大肠埃希氏菌。

图2 EC-MUG培养基微生物质控结果
计算EC-MUG阳性管数,查对应的最可能数(MPN)表(表1或表2)得出大肠埃希氏菌的最可能数,结果以MPN/100mL报告。
表1 大肠埃希氏菌(MPN)检索表(部分)
(总接种量55.5mL,其中5份10mL水样、5份1mL水样、5份0.1mL水样)

表2 用5份10 mL水样时各种阳性和阴性结果组合时的最可能数(MPN)

3.2大肠埃希氏菌滤膜法
用滤膜法检测水样后,将总大肠菌群阳性的滤膜在含有荧光底物的培养基上培养,能产生β-葡萄糖醛酸酶分解荧光底物释放出荧光产物,使菌落能够在紫外光下产生特征性荧光,以此来检测水中大肠埃
3.2.1 检验步骤
(1)准备工作
滤膜灭菌:将滤膜放入烧杯中,加入蒸馏水,置于沸水浴中煮沸灭菌3次,每次15min。前两次煮沸后需更换水洗涤2次~3次,以除去残留溶剂。
滤器灭菌:用点燃的酒精棉球火焰灭菌。也可用蒸汽灭菌器103.43kPa(121℃)高压灭菌20min。
(2)过滤水样
用无菌镊子夹取灭菌滤膜边缘部分,将粗糙面向上,贴放在已灭菌的滤床上,固定好滤器,将100mL水样(如水样含菌数较多,可减少过滤水样量,或将水样稀释)注入滤器中,打开滤器阀门,在-5.07×104Pa(负0.5大气压)下抽滤。
(3)培养
水样滤完后,再抽气约5s,关上滤器阀门,取下滤器,用灭菌镊子夹取滤膜边缘部分,移放在品红亚硫酸钠培养基上,滤膜截留细菌面向上,滤膜应与培养基完全贴紧,两者间不得留有气泡,然后将平皿倒置,放入37℃恒温箱内培养24h±2h。
(4)接种
挑取符合下列典型菌落生长的滤膜进行大肠埃希氏菌检测。
紫红色、具有金属光泽的菌落;
深红色、不带或略带金属光泽的菌落;
淡红色、中心色较深的菌落。
图3 质控菌株在品红亚硫酸钠培养基生长情况
注:A:大肠埃希氏菌ATCC 25922;B:大肠埃希氏菌ATCC 8739;C:弗氏柠檬酸杆菌ATCC 43864;D:鼠伤寒沙门氏菌ATCC 14028;E:粪肠球菌ATCC 29212;
在无菌操作条件下将滤膜转移到NA-MUG平板上,细菌截留面朝上,进行培养。将已接种的NA-MUG平板36℃±1℃培养4 h。
3.2.2 结果观察与报告
将培养后的NA-MUG平板在暗处用波长为366nm功率为6W的紫外光灯照射,如果菌落边缘或菌落背面有蓝色荧光产生则表示水样中含有大肠埃希氏菌。

图4 质控菌株在NA-MUG培养基生长情况
注:A:大肠埃希氏菌ATCC 25922;B:大肠埃希氏菌ATCC 8739;C:大肠埃希氏菌CMCC(B) 44102;D:鼠伤寒沙门氏菌ATCC 14028;
记录有蓝色荧光产生的菌落数,按下列公式计算滤膜上生长的大肠埃希氏菌数,以每100mL水样中的大肠埃希氏菌(CFU/100mL)报告。

3.3大肠埃希氏菌酶底物法
在选择性培养基上能产生β-半乳糖甘酶(β-D-galactosidase)分解色原底物释放出色原体使培养基呈现颜色变化,并能产生β-葡萄糖醛酸酶(β-glucuronidase)分解荧光底物释放出荧光产物,使菌落能够在紫外光下产生特征性荧光;以此技术来检测大肠埃希氏菌的方法为大肠埃希氏菌酶底物法。
3.3.1 检验步骤
(1)水样稀释
检测所需水样为100mL。若水样污染严重,可对水样进行稀释。取10mL水样加入到90mL灭菌生理盐水中,必要时可加大稀释度。
(2)定性反应
用100mL的无菌稀释瓶量取100mL水样,加入2.7g±0.5g的MMO-MUG培养基粉末,混摇均匀使之完全溶解后,放入36℃±1℃的培养箱内培养24h。
(3)10管法
用100mL的无菌稀释瓶量取100mL水样,加入2.7g±0.5g的MMO-MUG培养基粉末,混摇均匀使之完全溶解。
准备10支15mm×10cm或适当大小的灭菌试管,用无菌吸管分别从前述稀释瓶中吸取10mL水样至各试管中,放入36℃±1℃的培养箱中培养24h。
(4)51孔定量盘法
用100mL的无菌稀释瓶量取100mL水样,加入2.7g±0.5g的MMO-MUG培养基粉末,混摇均匀使之完全溶解。
将前述100mL水样全部倒入51孔无菌定量盘内,以手抚平定量盘背面以赶除孔穴内气泡,然后用程控定量封口机封口。放入36℃±1℃的培养箱中培养24h。

图5 51孔定量盘
3.3.2 结果报告
(1)结果判读
将水样培养24h后进行结果判读,如果结果为可疑阳性,可延长培养时间到28h进行结果判读,超过28h之后出现的颜色反应不作为阳性结果。
对照表同表3与表4,水样变黄色同时有蓝色荧光判断为大肠埃希氏菌阳性,水样未变黄色而有荧光产生不判定为大肠埃希氏菌阳性。

图6 质控菌株在MMO-MUG培养基中生长情况
注:A:大肠埃希氏菌ATCC 25922;B:阴沟肠杆菌ATCC 23355;C:弗氏柠檬盐杆菌ATCC 43864;D:肺炎克雷伯氏菌ATCC 10031;E:鼠伤寒沙门氏菌ATCC 14028;
(2)定性反应
将经过24h培养颜色变成黄色的水样在暗处用波长为366nm的紫外光灯照射,如果有蓝色荧光产生判断为阳性反应,表示水中含有大肠埃希氏菌。水样未产生蓝色荧光判断为阴性反应。结果以大肠埃希氏菌检出或未检出报告。
(3)10管法
将培养24h颜色变成黄色的水样的试管在暗处用波长为366nm的紫外光灯照射,如果有蓝色荧光产生则表示有大肠埃希氏菌存在。
计算有荧光反应的试管数,对照表3查出其代表的大肠埃希氏菌最可能数。结果以MPN/100mL表示。如所有管未产生荧光,则可报告为大肠埃希氏菌未检出。
表3 10管法不同阳性结果的最可能数(MPN)及95%可信范围(部分)

(4)51孔定量盘法
将培养24h颜色变成黄色的水样的定量盘在暗处用波长为366nm的紫外光灯照射,如果有蓝色的荧光产生则表示该定量盘孔穴中含有大肠埃希氏菌。
计算有荧光反应的孔穴数,对照表4查出其代表的大肠埃希氏菌最可能数。结果以MPN/100mL表示。如所有孔未产生荧光,则可报告为大肠埃希氏菌未检出。
表4 51孔定量盘法不同阳性结果的最可能数(MPN)及95%可信范围(部分)

GBT5750.12-2006 生活饮用水标准检验方法微生物指标 -标准*载下**
http://www.hopebiol.com/biaozhun-download.asp?id=166
注:本文属海博生物原创,未经允许不得转载。